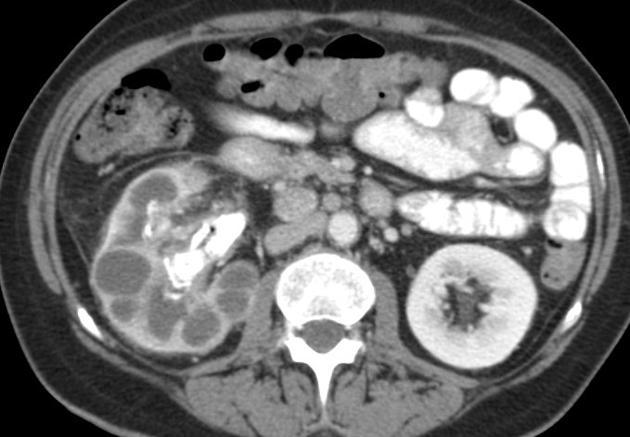

What is the most common type of RCC? Other types?
Most common RCC - clear cell (70-80%).
Next most common - papillary (15-20%). Less common types - chromophobe, sarcomatoid, medullary (sickle cell).
All enhancing renal masses that do not contain fat should be considered malignant unless proven otherwise by pathology.
What does reflux nephropathy look like?
Renal scarring overlying blunted calices, most severe at the poles (upper > lower). Scarring generally appears by age 4. May see compensatory hypertrophy of unaffected parts of the kidney.
What are the US findings of acute pyelonephritis?
How long can it take for imaging findings to resolve after clinical symptoms have resolved?
May be normal or may show increased or decreased echogenicity. On power doppler, absence of flow.
4-6 weeks.
What is acute papillary necrosis?
What are some predisposing conditions?
Symptoms?
Destruction of the renal papillae caused by ischemic or chemical injury to the papillae.
Analgesic nephropathy, dehydration, diabetes, UTI, and sickle cell.
Acute onset flank pain, fever, hematuria. Sloughed off papillae can cause renal colic.
Diagnosis?
What gives this imaging appearance?

Renal papillary necrosis.
Necrosis of the papillae leads to clefts, fissures, and cavities within and around the papillae. The affected papillae may slough off. This gives the appearance of extracaliceal contrast on CTP/IVP (ball on T). In chronic cases, may see calcified papillae.
What is the cause of horseshoe kidney?
Treatment?
Failure of the metanephric blastema to separate into 2 kidneys. A bar of tissue (isthmus) connects the lower poles of the kidneys.
None. Can divide the isthmus if it is interfering with drainage of the kidneys.
25 year old male. This is adjacent to but separate from the UVJ. Diagnosis?
Differential?

Hutch diverticulum. A congenital diverticulum, typically arising adjacent to the UVJ. Can cause recurrent UTI, vesicoureteric reflux. Wall made up of all 3 layers of bladder.
VS
Acquired bladder diverticula. Any location. Typically thinner wall- made up of prolapsed mucosa only. 2/2 obstruction, neurogenic bladder.
Urachal diverticulum. At the apex of the bladder, due to patent urachal remnant. 3 layers.
Diagnosis?
Complications?
Cause?

Uretheral diverticulum.
Dysuria, frequency/urgency, dyspareunia, stones, malignant degeneration (usually adenocarcinoma).
Can be cogenital (rare) or acquired, due to rupture of an obstructed and infected parauretheral gland into the uretheral lumen. Arises from the posterolateral aspect of the urethra.
Diagnosis?
MRI appearance?

Uterine leiomyoma.
MRI: T1 isointense to myometrium, T2 hypointense. (May be hyperintense on T1/2 if undergoing fatty degeneration) Signal dropout if calcifications.
Why are adrenal cortical adenomas <10 HU on noncontrast CT?
MRI appearance?
Because they are composed of cells with cholesterol-rich cytoplasm… cholesterol is the precursor of all adrenocortical hormones and is present in adrenal cortical cells.
Intracellular lipid in the form of cholestorol, so see signal dropout on out-of-phase images.
Diagnosis?
Differential?

Retroperitoneal liposarcoma.
Could also consider extrarenal angiomyolipoma. This would be more likely to have large vessels within the mass than liposarcoma is.
What is the main clue to the cause of a unilateral small kidney by imaging?
If the collecting system is normal sized, it’s probably due to chronic renal vascular disease (arterial or venous).
If the collecting system is enlarged, it’s probably secondary to postobstructive atrophy.
Congenital unilateral hypoplastic kidney is extremely rare. The contralateral kidney is always enlarged.
What side is the fused kidney more common on in crossed fused renal ectopia?
Where do the ureters insert?
The fused kidney is more common on the left.
In their normal position at the upper angles of the trigone. The ureter arising from the ectopic moeity (the lower one) crosses the midline to do this.
What is the most common cause of bilateral hydronephrosis and hydroureter?
Bladder outlet obstruction. Prostatic hypertrophy in men, pelvic floor dysfunction in women, posterior urethral valves in neonates.
What is the cause of testicular microlithiasis?
Risk?
Collections of debris in the seminiferous tubules from a defect in the phagocytic activity of Sertoli cells.
Increased risk of germ cell tumor.
What are the various Mullerian duct anomalies of the uterus?
Note- fusion of the Mullerian ducts should complete by the 18th week of fetal life.

What is the differential for an adrenal nodule that does and does not lose signal on out of phase imaging?
Loses signal: adrenal adenoma.
Doesn’t: lipid-poor adrenal adenoma, adrenal metastasis (bronchogenic carcinoma, melanoma, breast, and renal are most common), primary adrenal carcinoma.
Patient with shock and abdominal pain. Diagnosis?

Ruptured AAA.
Diagnosis?
What is this?
Complication?
Appearance on out-of-phase MRI?

Adrenal myelolipoma.
A benign neoplasm of the adrenal, composed of elements of bone marrow. Varying proportions of fat and myeloid cells. They can be composed of only myeloid cells “lipid-poor myelolipoma.” About 15% are extra-adrenal.
Hemorrhage.
They do not drop signal because the fat is macroscopic. They get india ink artifact around the fat.
Diagnosis?
Cause?

Adenomyosis.
Focal or diffuse invasion of endometrial tissue into the myometrium. Look for asymmetric thickening of the junctional zone (>12 mm), 50% have small cystic lesions in the myometrium. The endometrium looks normal.
Note- because the basal layer of the endometrium invades the myometrium, it does not show changes with the menstrual cycle.
What would be the most common primary testicular cancer in an older male? Very young male?
Nonseminomatous germ cell neoplasm for both. These include: teratomas, choriocarcinomas (elevated bHCG), embryonal cell carcinomas, and yolk sac tumors (elevated AFP). Most common in the 1st or 6th decade, tend to be complex on US with cystic and solid areas.
FYI, the primary testicular neoplasms are:
Germ cell: seminomatous (elevated bHCG) or nonseminomatous.
Non-germ cell: Sertoli-Leydig cell tumors.
What are some causes of calcified retroperitoneal lymphadenopathy?
Chronic granulomatous infection, metastatic disease from mucinous carcinoma of the colon or ovary, or treated lymphoma.
Diagnosis?
Causes?

Medullary nephrocalcinosis.
95% of cases are due to primary hyperparathyroidism, distal renal tubular acidosis (type 1), or medullary sponge kidneys.
But it can be caused by anything that causes hypercalcemia, hypercalciuria, or hyperoxaluria (others include milk alkalai syndrome, multiple myeloma, hypervitaminosis D, Cushing syndrome).
Diagnosis?
Cause?
Xanthogranulomatous pyelonephritis.
Abnormal reaction of the kidney to chronic infection (by Proteus most commonly). Causes masslike collections of foamy lipid-laden macrophages, may be focal or diffuse (more common). See complex fluid signal intensity lesions, parenchymal atrophy, and contracted renal pelvis. Staghorn (struvite) calculi present in 75%.








